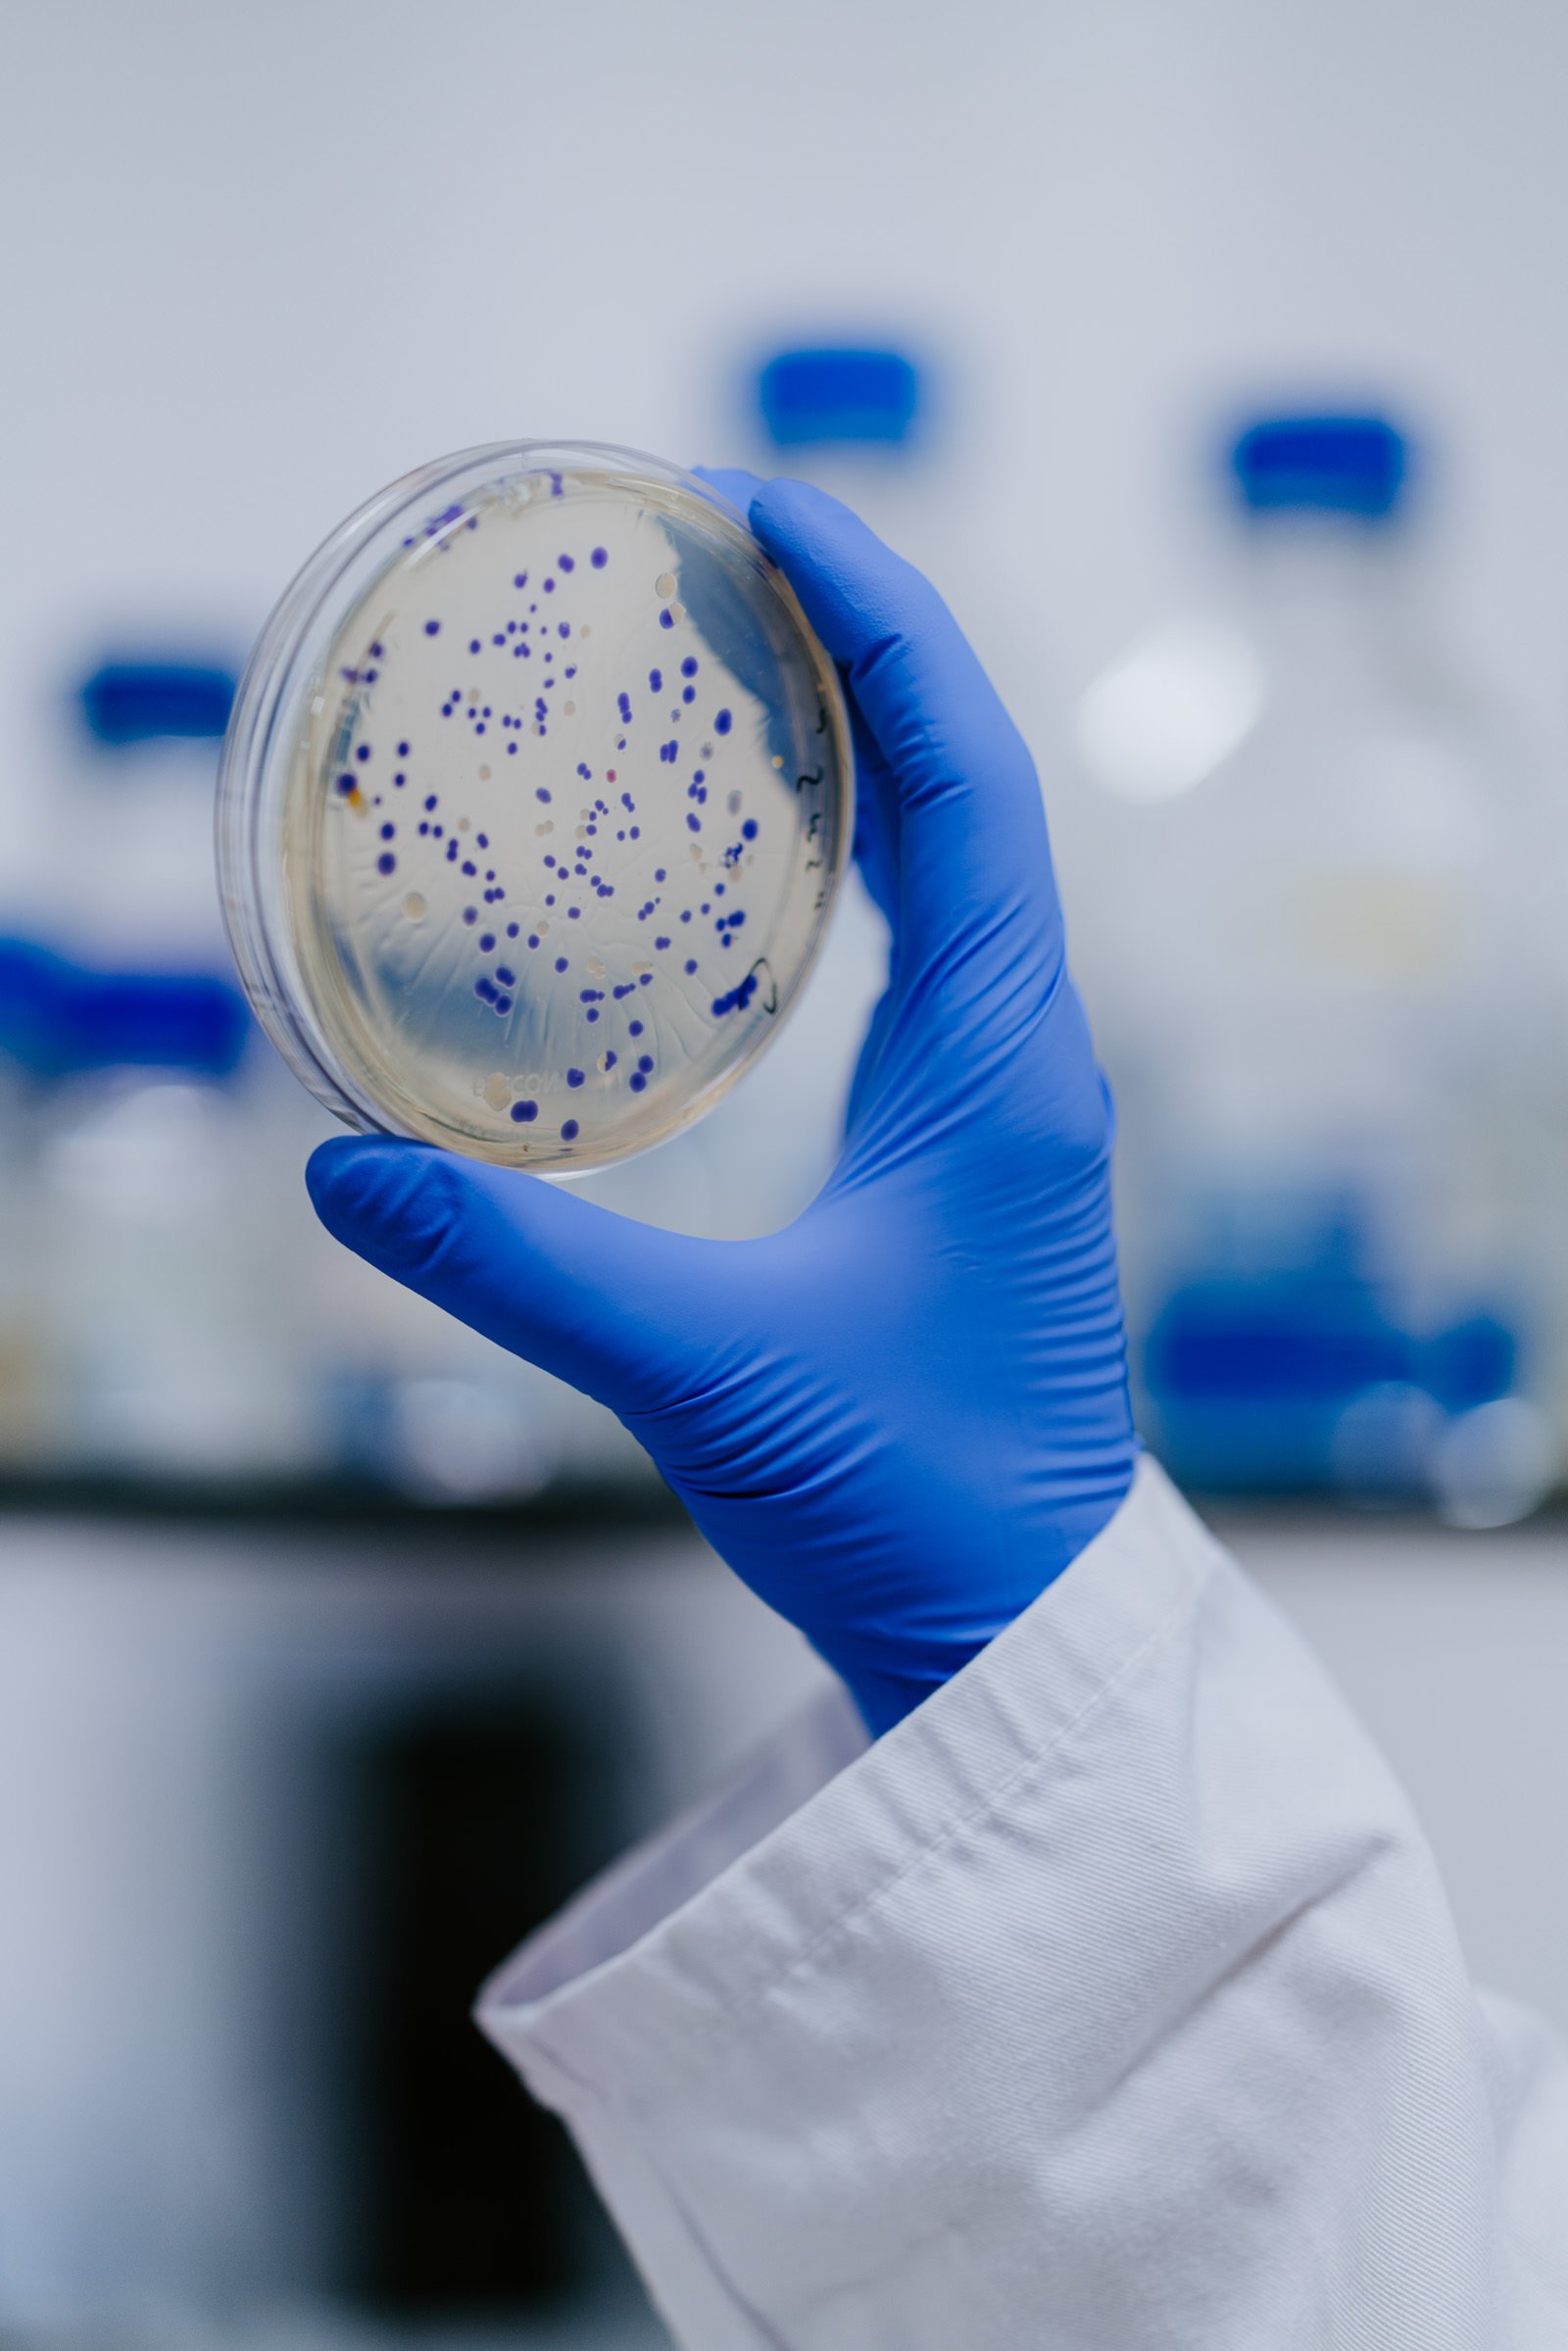
Biosciences 1600-21.jpg

Science & Industry
The client wanted shots to use on their website demonstrating their day to day laboratory work which was clean and technical, while still keeping the human element. Lab, office, team and site shots - 4 hour shoot
CLIENT - Pencil Biosciences

The client wanted a range of shots to use for their marketing, from meetings in headquarters, founder profile shots, documenting building work and finished construction projects, across 4 sites in the North West - 2.5 days shooting
CLIENT - Mountain Earth Construction



























The client wanted a range of shots to use for their marketing, from meetings, staff profile shots, documenting the factory, the laboratory and distribution methods - full day shoot
CLIENT - Baerlocher UK































